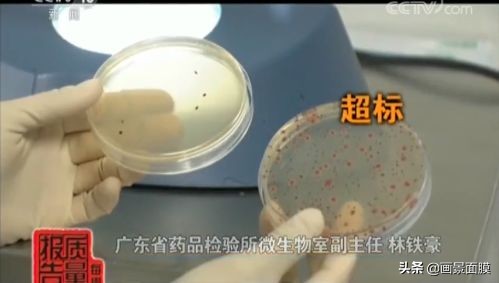

集美们晚上好~
兔姐昨天去国家药监局的网站上找资料的时候,发现最近又公布了一些不合格的化妆品名单


除了染发剂外,这些不合格的产品大多数都是面膜,我把这些不合格的面膜名单都给大家整理出来了,赶紧先来看看你踩雷了没有

想看完整版可以去药监局官网下载附件哦。
这些面膜上榜的理由,基本上都是菌落总数超标,超标程度不等,最“过分”的一款超标了整整87倍。(根据目前的规定,除眼、口、唇以及儿童化妆品外的其他化妆品,菌落总数不得大于1000CFU/mL 或1000CFU/g)

点击图片可放大
这种面膜敷在脸上,就相当于是把自己的脸当做的细菌培养皿,如果只是单纯的细菌,问题倒还没有特别严重,基本上只是会出现皮肤屏障受损一类的问题。
但如果这些细菌中存在致病菌,而此时恰巧你的皮肤上存在伤口,就很有可能会因此影响自己的身体健康,后果不堪设想。
左合格,右超标
值得庆幸的这些面膜大多都比较小众,购买渠道也比较有限,踩雷几率还是比较小的,但如果不幸买到了,建议大家还是赶紧丢掉为好。
不过就算是正规品牌生产的合格面膜,也会因为成分、使用感等原因,让我们把它“拉进黑名单”。
今天兔姐就给大家分享一下我的「面膜黑名单」,文末还有一些关于面膜的误区和知识点,记得看到最后哦~(放心吧没有广告)
*温馨提示:以下拔草理由仅针对我个人的使用感受,不同地区不同肤质的人,使用起来可能都会有不同的感受,大家理性看文,理性拔草。


对于我这种懒人来说,能在下班后的休息时间里爬起来敷一片面膜,已经是需要很大勇气了,佰草集这款冻干面膜更是能分分钟把我这颗想要敷面膜的心给劝退。
它的使用步骤和一般的面膜有些不同

STEP1:撕开面膜盒上的铝箔,取出盒内的铝箔袋
STEP2:撕开铝箔袋,把袋中的膜布放在面膜托中
STEP3:用量杯(附送的)接25ML的清水,倒入面膜托中
STEP4:静静等待一分钟
嗯,(懒人劝退)仪式感满满


当然啦,并不是所有人都像我一样容易犯懒,所以它(略显麻烦)仪式感满满的使用步骤并不是我把它拉进黑名单的主要原因。
这款面膜主打提亮肤色,成分中添加了7种可以起美白、抗氧化作用的成分,但添加量实在是不算多,都排在透明质酸的后面了,即时的美白效果还算不错,后续就马马虎虎吧。(哦对了,补水保湿的效果也没有很突出…)

<<<上下滑动查看全部成分>>>
虽然肤感和温和程度都是值得一夸的优点,但如果总体来看的话,与它单片将近30元的价格实在匹配不起来,性价比有点低,如果不并不在意价格和性价比的话倒是可以入手试试。


虽然我真的很喜欢兰蔻,但我也不得不站出来吐槽一下这款面膜…
它里面添加了酒精、水杨酸和高浓度的烟酰胺,色素含量不算低,香精味也比较重,所以大部分人涂它上脸后,可能都会出现泛红、刺痛之类的现象。
对烟酰胺不耐受、没建立耐受,以及敏感肌的集美可以暂时不用考虑它了。

<<<上下滑动查看全部成分>>>
官方介绍说它是个睡眠面膜,但它的质地真的很像胶水,敷在脸上半小时左右还依然是很黏头发的状态,涂着睡觉绝对会糊一枕头。
就算清洗掉后,也能明显感受到假滑的问题,保湿力也并不持久,对于健康皮来说,持续使用也并没有感受到很明显的美白效果。
虽然它在兰蔻的护肤产品中并不算贵,但我个人觉得也没什么太大必要买,毕竟好用的面膜还有很多嘛。


颐莲这个国货大家应该多多少少有听说过,它是福瑞达医药集团旗下的品牌,专注于玻尿酸护肤品的研发,它家的补水喷雾是我的常年必备,但对这款清洁面膜,我真是爱不起来。
它所用的清洁成分主要是蒙脱土和炭粉,吸附能力倒是没什么可说的,但它在泥膜中算干的比较慢的那一类,清洁效率就会比其他清洁面膜慢很多。
但你是不是想说「慢有什么关系,多敷一会不就好了?」 NONONO,我们来看看它的成分表


<<<上下滑动查看全部成分>>>
它选用的防腐剂都不算太温和的,尤其是甲基异噻唑啉酮,这个成分在脸上停留的时间越久,就越可能会出现过敏的现象。
所以想要清洁力,就得担着可能会过敏的风险,想要不过敏,就得舍弃一部分清洁力,这么看来着实有点鸡肋,建议想对它下手的集美再考虑考虑别的吧。


这款面膜我是抱着想多尝试新产品的想法去的,毕竟现在好用的国货有很多,说不定就又能发现一些物美价廉的产品呢,结果买回来一试,才深刻意识到就算买便宜的产品也要事前多做做功课…
这款面膜主打舒缓和补水,但我使用下来的感受是,这两个效果都非常一般,在我皮肤状态比较不稳定的时候,它几乎没有对我起到什么有效的帮助。
对成分有所了解的集美应该知道,黄原胶这个成分通常只要添加一点点就可以起效(通常在0.2%-2%),排在它后面的成分,添加量基本也不会太多。
所以单从它的成分表和我的使用感受来看,它的主打成分洋甘菊以及其他几种活性成分,添加在面膜里的意义并不算太大。

<<<上下滑动查看全部成分>>>
主要的保湿剂也就只有丙二醇这一种,但它也是比较便宜且普通的,补水保湿的效果还不如甘油。
当然啦,优点也是有的,就是它的价格真的很便宜,整体成分也比较温和,对敏感肌和学生党还是蛮友好的,预算有限且怕其他面膜会比较刺激的集美可以买来试试看。


美即的面膜我已经很多年没有用过了,某天逛超市的时候在货架上看见了它,或许是出于情怀(?),让我拿起了一片塞进了购物车里,到家用完后才庆幸还好只买了一片。
不喜欢它的理由其实就很简单,一是因为膜布太厚,敷起来觉得闷闷的,不太舒服;二是因为它的防腐剂添加量较多且刺激,在皮肤状态没有特别好的状态下会刺痛。

<<<上下滑动查看全部成分>>>
补水保湿的效果倒是还可以,但是冲它的成分和使用感,就算便宜我也不会再买了。

以我的性格来说,光拔草怎么能够呢,肯定是要再给大家留下点干货再结束的呀~所以在文章的最后,我就整理了几点关于面膜的Q&A,都是比较常见且大家比较关心的问题

Q:片状面膜敷完后一定要清洗掉吗?
A:最好洗掉。
因为面膜敷完后,残留在脸上的“精华”大多都是一些防腐剂、增稠剂,清洗掉可以防止毛孔堵塞之类的问题,也会更安心一些。
Q:面膜敷的时间越长越好吗?
A:当然不是。
在敷面膜的时候,皮肤会处在一个相对密闭的环境里,敷的时间太长,也会让皮肤过度水合,导致皮肤屏障受损,也很容易拔干。通常情况下,敷15-20分钟就可以了。
Q:洗完脸后可以直接敷面膜吗?
A:可以但不建议。
洗完脸后直接敷面膜虽然也没什么坏处,但如果敷之前用保湿水或肌底液打底的话,效果会更好哦~
Q:面膜冷藏后敷起来效果会更好吗?
A:不一定。
对于晒后修复的话,敷冷藏后的面膜可能会起到一定的帮助,但对于其他情况来说意义不大,而且如果总是把面膜从冰箱里拿进拿出,是会加速面膜变质的情况的。
Q:敷完面膜后拍脸可以促进吸收吗?
A:最好不要。
拍脸这个动作本身对于促进吸收的意义就算太不大,而且刚敷完面膜的时候,脸部的皮肤会处于一个比较脆弱的状态,再用力拍脸可能会容易导致皮肤屏障受损哦~所以敷完面膜后稍微按摩一下就可以了,拍打实在没必要。

好啦,今天关于面膜的内容到这里就结束辽~
最后再跟大家解释一下,我并不是有意要去说这些产品或是品牌的坏话,只是想把我个人对这些产品的感受说出来,分享给大家,避免踩雷。
毕竟大家的肤质和使用情况可能都会不同,所以有不同的使用感受也是非常正常的事情,还是那句话,理性看文,理性拔草哦~

版权声明:CosMeDna所有作品(图文、音视频)均由用户自行上传分享,仅供网友学习交流。若您的权利被侵害,请联系删除!
本文链接://www.cosmedna.com/article/518449522.html





































